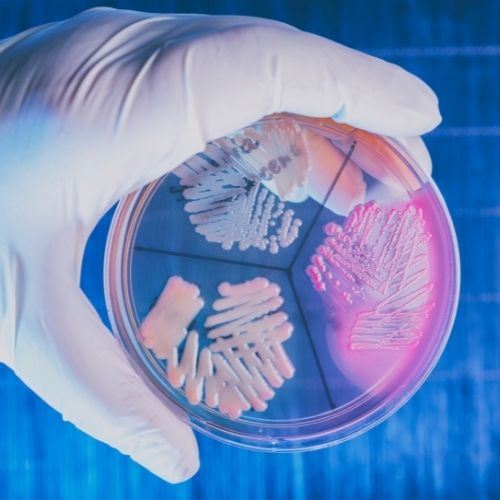
Clinical-Pathology.jpg

R.K. Pathology is a state-of-the-art laboratory located in Varanasi, dedicated to providing high-quality diagnostic services. Our highly skilled staff operates from a fully computerized central processing lab. Founded by professionals with extensive experience in the medical field, we utilize advanced technology for accurate pathology testing and seamless results delivery.

Channel Partner's
Permanent Staff
Popular Test
Happy Clients
RK Pathology is state of art laboratory with highly skilled staff having its main central processing lab in Greater Noida. Our founders have vast experience in the medical field and has specialized in technology application in pathology testing and process.